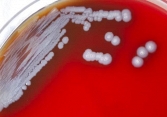
Nhiễm khuẩn là 'nguyên nhân gây tử vong thứ hai trên toàn thế giới'

Mạch máu không chịu nổi "kẻ thù" này: 5 thói quen sau khi ăn no âm thầm khiến đột quỵ trầm trọng hơn
Nguyên nhân gây đột quỵ thường nằm trong sinh hoạt hàng ngày. 5 thói quen sau bữa ăn này có thể là khiến bệnh trầm trọng hơn.
Sáng dậy mà thấy 4 điều này thì đừng đổ tại ‘ngủ chưa đủ’ nữa: Cơ thể đang kêu cứu vì mỡ máu quá cao!
Nhiễm khuẩn là 'nguyên nhân gây tử vong thứ hai trên toàn thế giới'
Nhiễm trùng do vi khuẩn là nguyên nhân gây tử vong đứng thứ hai trên...
Hà Nội ghi nhận số ca mắc sốt xuất huyết tăng hơn 4 lần so với năm 2021
TP đã ghi nhận 1.043 ổ dịch tại toàn bộ 30/30 quận, huyện, thị xã....
Làm thế nào để giữ cho đôi tai luôn sạch sẽ?
Có nhiều cách đơn giản và lành mạnh để đảm bảo đôi tai của bạn...
6 dấu hiệu mang thai đáng ngạc nhiên bạn có thể không biết
Một số dấu hiệu có thể xuất hiện rất sớm, thậm chí trước khi que...
Thu hồi 6 lô thuốc kháng sinh trị nhiễm khuẩn Greaxim
Cục Quản lý Dược (Bộ Y tế) thông báo đình chỉ lưu hành, thu hồi 6 lô...
Hàng trăm học sinh trường Ischool Nha Trang nhập việc cấp cứu vì ngộ độc sau buổi ăn trưa
Trên một trăm học sinh tại Trường THPT iSchool Nha Trang, TP Nha Trang (Khánh...
Những loại củ quả không nên ăn vỏ
Có một số loại rau củ nếu ăn cả vỏ có thể gây bệnh hoặc chứa...
5 nguyên nhân gây ra cơn đau đầu và cách chữa trị đơn giản
Tìm hiểu cách để có thể giảm bớt cơn đau đầu hoặc thậm chí ngăn...
Lần đầu tiên tại Việt Nam thực hiện ghép da thành công từ người hiến chết não
Bệnh nhân ghép da là trường hợp mảnh da ghép được tiếp nhận từ...
6 bài tập nhỏ giúp bạn đốt cháy calo cả khi ngồi
Có những bài tập có thể thực hiện khi ngồi trên ghế giúp bạn tăng...
Thẩm mỹ viện Ngọc Dung bị đình chỉ hoạt động 3 tháng
Theo thông tin Cổng thông tin điện tử ngành Y tế TP.HCM, Thanh tra Sở Y tế...
Vinamilk và CLB điều dưỡng trưởng hoàn thành chuỗi tập huấn nâng cao kiến thức dinh dưỡng
Từ 13/10-05/11/2022, công ty Vinamilk và ngành hàng sữa bột đã tiếp tục...
Số ca sốt xuất huyết ở TPHCM tăng cao gấp 7 lần so với năm ngoái
Từ đầu năm đến nay, TPHCM đã có 29 trường hợp tử vong vì SXH, tăng 24...
Lưỡi trắng là bệnh gì và phải làm gì khi mắc phải?
Bài viết này chỉ mang tính chất cung cấp thông tin và không thể thay thế...
Nghiên cứu mới: Người nhiễm Covid-19 nhiều lần có nguy cơ tử vong cao hơn chỉ nhiễm 1 lần
Những bệnh nhân mắc Covid-19 lặp lại có nguy cơ gặp các vấn đề về...
4 mẹo hay có thể ngăn ngừa tình trạng tóc bạc sớm
Bạn có thể áp dụng một số biện pháp chủ động dưới đây để trì...
6 cách để tăng cường hệ miễn dịch khi cơ thể ngày càng già đi
Điều tốt nhất mỗi người có thể làm là cố gắng chăm sóc bản...
Bệnh đường hô hấp tăng do hệ miễn dịch yếu sau COVID-19
Số ca mắc bệnh hô hấp ngày càng tăng mạnh trong thời gian gần đây ở...